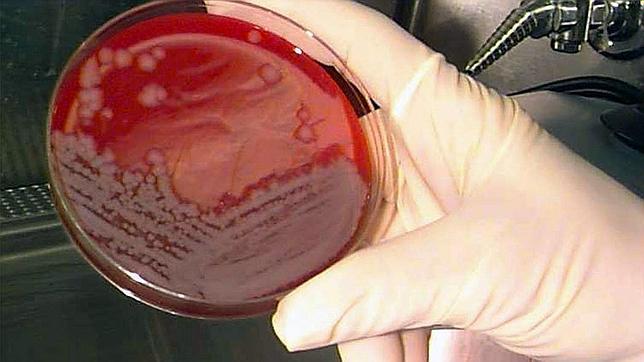
Decenas de científicos pueden haber estado expuestos al ántrax en un laboratorio de Atlanta

Decenas de científicos pueden haber estado expuestos al ántrax en un laboratorio de Atlanta
Los investigadores, ahora en tratamiento, pudieron entrar en contacto con la bacteria viva en un centro de bioseguridad de alto nivel del gobierno de EE.UU.
Reuters/EP
Unos 75 científicos que trabajan en laboratorios del Gobierno federal de Estados Unidos en Atlanta podrían haber estado expuestos a la bacteria viva del carbunco -ántrax- y están siendo tratados para evitar la infección, según han confirmado este jueves los Centros para el Control y ... Prevención de Enfermedades (CDC) del país.
La posible exposición ocurrió cuando investigadores de un laboratorio de bioseguridad de alto nivel de la agencia en Atlanta no siguieron los procedimientos apropiados para desactivar la bacteria.
Los investigadores trasladaron las muestras, que contenían la bacteria viva, a laboratorios de los CDC con estándares de seguridad menores y que no estaban equipados para manipular sustancias contaminadas con ántrax.
El doctor Paul Meechan, director de la oficina de seguridad de los CDC, ha explicado que la agencia descubrió la posible exposición el viernes 13 de junio por la noche e inmediatamente comenzó a contactar a los individuos que trabajan en los laboratorios ante el peligro de que hayan manipulado sin saberlo sustancias contaminadas con la bacteria.
"Ningún empleado ha mostrado síntomas de enfermedad de ántrax maligno", ha dicho Meechan a Reuters. El experto ha añadido que el periodo normal de incubación puede durar entre cinco y siete días, pero se han documentado casos en que la enfermedad se presenta 60 días después de la exposición.
Meechan ha añadido que un máximo de siete investigadores podrían haber tenido contacto directo con la bacteria viva del carbunco. Por ello, la agencia ha puesto en marcha medidas preventivas extensas para asegurarse de que todos sus empleados que hayan pasado por cualquiera de los laboratorios en riesgo reciban tratamiento.
Unos 75 individuos está siendo sometidos a un tratamiento de 60 días con antibióticos y la vacuna contra el carbunco o ántrax maligno.
Investigación del FBI
El FBI está trabajando con los Centros para el Control y la Prevención de Enfermedades en la investigación para aclarar el posible caso de exposición al ántrax de científicos del gobierno en un laboratorio en Atlanta. Sin embargo, el portavoz del FBI, Paul Bresson, ha avanzado que, por el momento, no han encontrado evidencias del suceso.
El manejo de patógenos dentro de los laboratorios del Gobierno de Estados Unidos ha sido una preocupación cada vez mayor desde 2008, cuando el FBI identificó a Bruce Ivins, un investigador de ántrax del Ejército estadounidense, como el principal sospechoso de una serie de ataques de cartas con ántrax en 2001.
El ántrax por inhalación se reproduce en dos etapas. En la primera etapa, los síntomas se asemejan a un resfriado o la gripe, mientras que en la segunda etapa el ántrax causa fiebre, dificultad respiratoria severa y shock. Alrededor del 90% de las personas que se encuentran en esta segunda etapa por inhalación de ántrax mueren, incluso después de un tratamiento con antibióticos.
Decenas de científicos pueden haber estado expuestos al ántrax en un laboratorio de Atlanta
Noticias relacionadas
Esta funcionalidad es sólo para suscriptores
Suscribete
Esta funcionalidad es sólo para registrados
Iniciar sesiónEsta funcionalidad es sólo para suscriptores
Suscribete